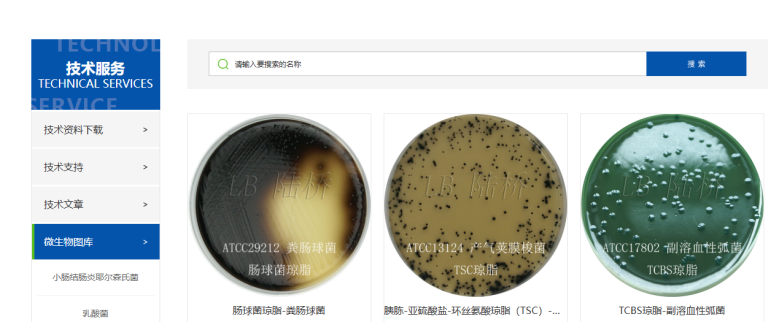
【技術(shù)干貨匯總】2025年度常見技術(shù)問題大盤點(diǎn)

當(dāng)2025年的最后一頁日歷輕輕落下,2026年的曙光已在地平線緩緩鋪開。在這承前啟后的時(shí)刻,我們都是時(shí)光的盤點(diǎn)者。每一個(gè)微生物檢驗(yàn)實(shí)驗(yàn)室的工作人員都在干著一件相同的事----年終總結(jié)?。?!
回顧2025年,陸橋技術(shù)團(tuán)隊(duì)的足跡清晰可辨。在實(shí)驗(yàn)室,平皿與數(shù)據(jù)相伴,見證著我們對培養(yǎng)基性能的驗(yàn)證與精益求精。走出實(shí)驗(yàn)室,我們的身影又出現(xiàn)在全國多個(gè)城市的展會(huì)會(huì)場和客戶單位,通過培訓(xùn)和交流,解答您工作中的疑惑。
當(dāng)然,無論何時(shí)何地,那座最便捷的橋梁,始終是靜靜守候在您耳畔的客服熱線。我們始終在線,確保每一次詢問,都有回響。
2025年,三千余通來電,在客服中心交織成一條無形的聲波紐帶。每一通電話背后,都是一個(gè)真切的需求:或許是尋找一個(gè)準(zhǔn)確的貨號,或許是探討產(chǎn)品的某項(xiàng)參數(shù),更多時(shí)候,是帶著具體問題而來的技術(shù)探討。
我們珍視這些來自一線的聲音。歲末之際,我們將這一年的“聲音檔案”進(jìn)行梳理、歸納與提煉,將其凝聚為若干最具代表性的10個(gè)常見技術(shù)問題。在此與各位分享,盼能以我們共同的實(shí)踐與思考,相互啟迪,攜手前行。
一、培養(yǎng)基驗(yàn)收類問題
1. 是否需要按照GB 4789.28-2024開展培養(yǎng)基驗(yàn)收?
根據(jù)實(shí)際需求決定是否開展培養(yǎng)基驗(yàn)收。GB 4789.28-2024標(biāo)準(zhǔn)5.2.1條款中明確要求“如果生產(chǎn)商能提供具備相應(yīng)檢驗(yàn)?zāi)芰?,并取得國家相關(guān)認(rèn)證認(rèn)可資質(zhì)檢驗(yàn)機(jī)構(gòu)出具的同批次產(chǎn)品檢驗(yàn)報(bào)告,實(shí)驗(yàn)室可保留相關(guān)證明文件,根據(jù)實(shí)際需求對該批次培養(yǎng)基的性能進(jìn)行重復(fù)測試”。
因此,前提條件是該批次培養(yǎng)基需要具備第三方檢驗(yàn)報(bào)告(CNAS報(bào)告),目前陸橋產(chǎn)品,凡屬于GB4789系列標(biāo)準(zhǔn)使用的培養(yǎng)基,無論干粉還是顆粒,均可以在陸橋官網(wǎng)下載第三方檢驗(yàn)報(bào)告(CNAS報(bào)告)。有了第三方檢驗(yàn)報(bào)告(CNAS報(bào)告)之后,您可以根據(jù)自身實(shí)際需求決定是否開展培養(yǎng)基驗(yàn)收。從對自身產(chǎn)品質(zhì)量和企業(yè)聲譽(yù)負(fù)責(zé)的角度,我們建議您在不影響日常檢驗(yàn)工作的情況下,開展培養(yǎng)基驗(yàn)收。
2. 瓊脂類培養(yǎng)基如何進(jìn)行pH測定?
目前GB 4789.28-2024標(biāo)準(zhǔn)中,培養(yǎng)基和試劑的質(zhì)量要求中不涵蓋pH值的要求。如要測定培養(yǎng)基的pH值,可參考GB 4789.28-2013版標(biāo)準(zhǔn)中使用pH計(jì)進(jìn)行測量;對于瓊脂類的培養(yǎng)基,因其在25℃時(shí)處于凝固狀態(tài),標(biāo)準(zhǔn)中也未規(guī)定使用何種形式的電極進(jìn)行測定,建議使用能夠測定半固體及固體樣品的電極。
二、培養(yǎng)基使用時(shí)遇到的問題
1. 培養(yǎng)基加熱煮沸的方式和方法?
建議使用微波爐+電陶爐的組合方式進(jìn)行加熱煮沸。先用微波爐預(yù)熱,可有效避免糊底現(xiàn)象,再用電陶爐煮沸,方便觀察沸騰并及時(shí)挪開,避免培養(yǎng)基噴濺的情況。具體操作可以參看我們的“煮沸滅菌”視頻。
若您使用的是電磁爐,建議沸騰后轉(zhuǎn)小火,讓培養(yǎng)基沸騰1min-2min,使之充分溶解。煮沸后分裝于滅菌的三角瓶中。
培養(yǎng)基煮沸滅菌操作
(點(diǎn)擊上方超鏈接,觀看完整視頻↑)
2. 干粉培養(yǎng)基開封后能存放多久?
GB 4789.28-2024標(biāo)準(zhǔn)中未提及開封后存放時(shí)間,根據(jù)我們經(jīng)驗(yàn),存放時(shí)間取決于培養(yǎng)基受潮情況。簡單判定方法是:培養(yǎng)基干粉流動(dòng)性良好,沒有結(jié)塊,且在保質(zhì)期內(nèi),一般都可以使用。培養(yǎng)基宜存放在陰涼干燥處,因此,存放點(diǎn)需遠(yuǎn)離高壓鍋和洗刷間,這兩處地方一般水汽較重,培養(yǎng)基易受潮。同時(shí),北方地區(qū)相對干燥,培養(yǎng)基開封后存放時(shí)間也普遍長于相對潮濕的南方地區(qū)。
三、標(biāo)準(zhǔn)菌株相關(guān)問題
1. 標(biāo)準(zhǔn)菌株如何進(jìn)行活化、傳代和保藏?
1) 根據(jù)所購買標(biāo)準(zhǔn)菌株的菌株編號確定相應(yīng)的菌種保藏機(jī)構(gòu)
2) 根據(jù)菌株編號或批號到該菌種保藏機(jī)構(gòu)下載使用說明書(ATCC系列可于北京陸橋官網(wǎng)下載使用說明----ATCC菌株推薦活化方法與條件)
ATCC菌株推薦培養(yǎng)條件
(點(diǎn)擊上方超鏈接,觀看完整內(nèi)容↑)
3) 根據(jù)說明書的指引選擇合適的培養(yǎng)基和培養(yǎng)條件對標(biāo)準(zhǔn)菌株進(jìn)行活化和傳代(具體試驗(yàn)操作可參考陸橋官網(wǎng)視頻--標(biāo)準(zhǔn)菌株的活化)
標(biāo)準(zhǔn)菌株的活化
(點(diǎn)擊上方超鏈接,觀看完整視頻↑)
4) 根據(jù)實(shí)驗(yàn)室條件選擇合適的菌種保藏方法,推薦使用超低溫保藏法和傳代保藏法對標(biāo)準(zhǔn)菌株進(jìn)行保藏。(具體試驗(yàn)操作可參考陸橋官網(wǎng)視頻--菌株的保藏及活化)
菌株的保藏及活化
(點(diǎn)擊上方超鏈接,觀看完整視頻↑)
四、微生物檢驗(yàn)相關(guān)問題
1. 如何判斷平板上菌落特征是否典型?是否需要進(jìn)行生化鑒定?
菌落是否典型首先看相應(yīng)檢驗(yàn)標(biāo)準(zhǔn)上關(guān)于典型菌落特征的文字描述。如果符合典型特征的描述,或認(rèn)為是可疑的菌落特征,都應(yīng)該進(jìn)行相應(yīng)的生化鑒定。實(shí)際工作中,有些實(shí)驗(yàn)室沒有標(biāo)準(zhǔn)菌株,所以沒有親眼見過平板上的典型菌落具體是什么樣子,如果只看文字描述,無法想象菌落具體的特征。這時(shí)可以登錄我們網(wǎng)站,常見檢驗(yàn)項(xiàng)目的典型菌落特征均有圖片展示,可以幫助大家更好的判定菌落是否典型。
微生物圖庫
(點(diǎn)擊上方超鏈接,觀看完整內(nèi)容↑)
2. 生化結(jié)果如何判定?
嚴(yán)格按照相應(yīng)檢驗(yàn)標(biāo)準(zhǔn)上的生化項(xiàng)目進(jìn)行判定。
如果是某個(gè)生化項(xiàng)目無法判定陰陽性,有條件的可以借助標(biāo)準(zhǔn)菌株輔助觀察,也可以參考我們官網(wǎng)的圖片,地址同上。
如果所有生化項(xiàng)目的結(jié)果已經(jīng)判定,但是不知道如何看相應(yīng)標(biāo)準(zhǔn),不知道最終檢驗(yàn)項(xiàng)目是檢出還是未檢出。那么就需要加強(qiáng)標(biāo)準(zhǔn)的學(xué)習(xí)了,根據(jù)我們客服電話的匯總,大部分遇到此類情況的實(shí)驗(yàn)室都是檢驗(yàn)沙門氏菌的,因?yàn)樯抽T氏菌的結(jié)果判定較為復(fù)雜。那么可以參看我們曾經(jīng)推出的《沙門氏菌屬傳統(tǒng)生化鑒定要點(diǎn)解析》。
沙門氏菌屬傳統(tǒng)生化鑒定要點(diǎn)解析
(點(diǎn)擊上方超鏈接,觀看完整內(nèi)容↑)
3. 做菌落總數(shù)時(shí)如何區(qū)分平板上出現(xiàn)的是菌落還是樣品殘?jiān)?/span>
在菌落總數(shù)項(xiàng)目中經(jīng)常會(huì)有樣品(渣狀或小顆粒)或細(xì)小菌落(生長較慢且偏?。└蓴_判斷的情況出現(xiàn),針對此問題,有幾種解決方案:
1) 在處理可能會(huì)有渣子或異物樣品時(shí),建議使用帶濾膜的均質(zhì)袋;

2)陸橋測試片可使菌落顯色,避免樣品殘?jiān)母蓴_,對于含有殘?jiān)6嗟臉悠?,建議選擇陸橋測試片進(jìn)行計(jì)數(shù)。
3)可以實(shí)驗(yàn)中設(shè)立樣品陰性對照(接樣后放2-8℃冰箱)或延長培養(yǎng)時(shí)間,陰性對照可用來和干擾顆粒進(jìn)行比對,延長培養(yǎng)看干擾顆粒是否變大,如變大則是微生物,若和陰性對照一致或不變大,則可能為樣品干擾所致。
五、標(biāo)準(zhǔn)變更相關(guān)問題
1. 2025版新頒布的國標(biāo)與之前版本國標(biāo)有哪些變化?
近幾年國標(biāo)更新速度明顯加快,幾乎每年都有重量級標(biāo)準(zhǔn)更新。陸橋技術(shù)團(tuán)隊(duì)均會(huì)在第一時(shí)間核對新舊標(biāo)準(zhǔn)的變化點(diǎn),特別是培養(yǎng)基的變化點(diǎn),并在陸橋微信公眾號和官方網(wǎng)站以推文形式發(fā)布新標(biāo)準(zhǔn)解析。所以想了解近幾年標(biāo)準(zhǔn)的變化點(diǎn),大家可隨時(shí)查閱我們陸橋公眾號及網(wǎng)站文章。
2025版大腸菌群標(biāo)準(zhǔn)修訂亮點(diǎn)
GB4789.30-2025單核細(xì)胞增生李斯特氏菌標(biāo)準(zhǔn)變化
GB 4789.38-2025《食品安全國家標(biāo)準(zhǔn) 食品微生物學(xué)檢驗(yàn) 大腸埃希氏菌計(jì)數(shù)》解讀
(點(diǎn)擊上方超鏈接,觀看完整內(nèi)容↑)
六、培養(yǎng)基原理相關(guān)問題
1. 培養(yǎng)基中某個(gè)成分有什么作用?
近年來咨詢培養(yǎng)基中成分作用的來電越來越多,說明大家的技術(shù)水平都在提升,不僅要知其然,還要知其所以然。為滿足大家的知識(shí)需求,我們陸橋早在2007年就已經(jīng)編撰并出版了《微生物干粉培養(yǎng)基質(zhì)控圖解手冊》,書中將常見培養(yǎng)基的原理解釋的非常清楚。隨著技術(shù)進(jìn)步,近些年我們又將培養(yǎng)基原理搬到了官網(wǎng)上,需要了解培養(yǎng)基原理的檢驗(yàn)員可是隨時(shí)登錄我們官網(wǎng)查詢通過產(chǎn)品名稱或貨號查看產(chǎn)品詳情。下圖是我們官網(wǎng)上XLD瓊脂的原理。

XLD瓊脂產(chǎn)品詳情頁
(點(diǎn)擊上方超鏈接,觀看完整內(nèi)容↑)
以上,便是我們從2025年“聲音檔案”中,為您凝練出的常見技術(shù)問答。愿這份源于實(shí)踐、歸于實(shí)踐的總結(jié),能為您的工作帶來切實(shí)助益。
時(shí)序更迭,服務(wù)常新。在新的一年里,無論是復(fù)雜的技術(shù)挑戰(zhàn),還是即時(shí)的產(chǎn)品咨詢,我們的技術(shù)熱線 010-85786931 將始終如一,靜候您的來電,期待與您的下一次專業(yè)對話。